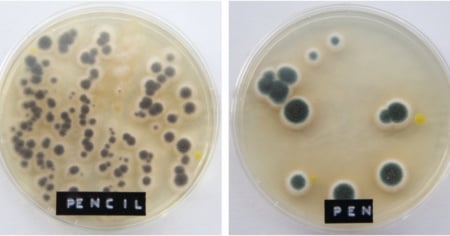

Virus, muffe e batteri: ecco cosa c'è nei nostri uffici
Con l'arrivo dell'influenza (ma non solo) pulito è meglio
Con l'arrivo dell'influenza (ma non solo) pulito è meglio
LUGANO - Le influenze di stagione stanno per tornare. Secondo le statistiche faranno la loro comparsa verso la fine dell'anno. E i virus si nascondono ovunque, anche in ufficio. Anzi, a volte è proprio l'ambiente di lavoro ad essere focolaio per spiacevoli malanni. Qualcosa, tuttavia, si può fare.
Mantenere pulite il più possibile le aree di lavoro e gli spazi comuni, per esempio, è un primo e importante passo per ridurre il rischio di trasmettersi l’influenza in ufficio.
Alcuni virus, infatti, possono sopravvivere settimane intere su superfici come scrivanie o piani di lavoro ma, ancor di più, sulle tastiere dei computer.
Gli autori del blog Coffee Break hanno voluto vederci chiaro. Come? facendo crescere alcune culture batteriche per capire quali e quanti germi che ci circondano ogni giorno.
Il tutto grazie a un tampone passato su alcune superfici e oggetti d'uso comune in ufficio. I risultati sono... disgustosi e affascinanti allo stesso tempo. I risultati sono riportati qui di seguito.
I risultati - Dopo cinque le colture batteriche e i funghi si sono moltiplicati esponenzialmente. Gli organismi presenti erano principalemnte muffe (colonie blu), stafilococchi (spesso provengono dalle mani e dalle mucose del naso) e enterobatteri (indicatori dell’igiene ambientale).
Mouse (appena pulito)

Poiché il mouse era stato appena pulito la crescita è stata quasi nulla. Ciò ha dimostrato ancora di più l’importanza di pulire regolarmente gli oggetti e le superfici di lavoro, soprattutto quando qualcuno nel vostro ufficio è malato.
Scrivania

Il campione preso dalla scrivania ha mostrato la più vasta gamma di batteri, funghi, ecc… La tendenza di molti di mangiare sulla scrivania è probabilmente un fattore responsabile di questi risultati
Fotocopiatrice
La fotocopiatrice si è dimostrata molto più sporca di quanto sembrasse. Ciò è probabilmente dovuto al fatto che è utilizzata da molte persone, ma anche che le sue superfici non vengono pulite con regolarità.
Bollitore dell’acqua

Il bollitore per l’acqua dell’ufficio ha mostrato una crescita interessante e unica, differente rispetto a quella degli altri campioni. Questo si deve anche al fatto che il tampone è stato preso su un’area solitamente molto più calda rispetto al resto dell’ufficio.
Maniglia della porta
La porta invece non è stata altrettanto sorprendente e la crescita di microrganismi è stata limitata in confronto agli altri campioni. Probabilmente ciò è dovuto al fatto che è pulita ogni giorno dagli addetti alle pulizie dell’ufficio. Però questo rende la crescita osservata ancora più rilevante, in quanto frutto di un solo giorno di esposizione e contatti, e dimostra quanto un oggetto possa essere un punto di contagio anche se quotidianamente pulito.
Matita e Penna “masticate”

La matita e la penna “mangiate” sembrano essere il rifugio ideale per molti germi. In questo caso il problema è che, se qualcuno mastica una penna, crea un punto di contagio che poi è portato in giro; prestandola a un collega, lo si espone al rischio di essere attaccato da orde di germi e batteri che potrebbe farlo ammalare. Per di più se la penna è già contaminata, chi la mastica si porta direttamente la contaminazione in bocca.
Telefono e Tastiera

I campioni presi su telefono e tastiera sono stati sorprendenti per la relativa assenza di sviluppi. Questo può semplicemente derivare dal fatto che le superfici erano state pulite di recente.
Pulito è meglio - La conclusione è semplice: occorre lavarsi le mani con acqua calda e sapone ogni volta è necessario e mantenere il posto di lavoro pulito e curato giornalmente con dei detergenti.








